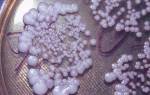

Своевременное и правильное лечение остеохондроза любого отдела позвоночника в 70% случаях оказывает положительное влияние. Острая стадия болезни характеризуется болевыми ощущениями, припухлостями, нарушением работы головного мозга. Для исправления ситуации рекомендуется принимать сосудорасширяющие препараты.
Принцип действия сосудорасширяющих препаратов
При развитии остеохондроза сужается просвет сосудов, нарушаются обменные процессы и питание тканей, что ведет к меньшему поступлению в них крови. Регулировать диаметр сосудистого просвета можно при помощи воздействия на гладкие мышцы стенок. При их неконтролируемом сокращении (болевом спазме) возникает опухоль, которую можно снять только приемом специальных медикаментов.
Врачи часто назначают пациентам сосудорасширяющие препараты при остеохондрозе шеи. Их принцип действия:
- ослабляют болевой нервный импульс, блокируют его влияние на гладкие мышцы стенок сосудов, не допуская развития спазмов (нейротропные препараты);
- напрямую влияют на мышцы сосудов, заставляя увеличивать их просвет (миотропные медикаменты).
Лучше принимать сосудорасширяющие препараты для работы головного мозга при остеохондрозе в комплексе, чтобы улучшить циркуляцию крови в пораженных позвонках, устранить застойные явления, предупредить развитие негативных процессов и атрофию мышц. Прием сосудорасширяющих препаратов постепенно нормализует естественную передачу нервных импульсов к кровеносным сосудам, исключает появление нежелательных симптомов.
Статьи по теме
- Препараты калия и магния при судорогах – перечень медикаментов с описанием, составом и противопоказаниями
- Таблетки от внутричерепного давления у взрослых – список препаратов с описанием, составом и дозировкой
- Препараты при инсульте головного мозга – схема приема медикаментов во время приступа и при восстановлении
Мнение врачей:
Сосудорасширяющие препараты для головного мозга могут быть полезны при остеохондрозе шеи, считают врачи. Это связано с тем, что при данном заболевании часто наблюдается нарушение кровообращения в области шеи, что может привести к снижению поступления кислорода и питательных веществ в мозг. Сосудорасширяющие препараты способствуют расширению сосудов, улучшая кровоток и обеспечивая лучшее питание мозговых клеток. Однако перед началом приема таких препаратов необходимо проконсультироваться с врачом, чтобы подобрать оптимальную дозировку и учесть индивидуальные особенности пациента.

Препараты для сосудов головного мозга и шеи
Применяя сосудистые препараты при шейном остеохондрозе, пациент избавляется от сильных головных болей, возникающих в результате нарушения кровоснабжения головного мозга. Средства купируют устойчивый спазм позвоночных артерий, устраняют тошноту, слабость, вялость движений, нарушение концентрации. Схема лечения остехондроза включает комплекс средств: вазодилататоры, ноотропы и наружные мази.
Вазодилататоры
Сосудорасширяющие препараты для головного мозга при остеохондрозе из группы вазодилататоров улучшают кровоток в пораженном месте, облегчают самочувствие, снимают головную боль, нормализуют мозговую активность и кровоснабжение. К ним относятся:
|
Эуфиллин |
Пентоксифиллин |
Никотиновая кислота |
|
|
Действие |
Расслабляет гладкую мускулатуру, уменьшает гиперреактивность мышц, увеличивает кровоток |
Улучшает реологические свойства крови, микроциркуляцию, снижает общее периферическое сопротивление сосудов |
Расширяет мелкие сосуды, нормализует кровообращение, обладает антикоагулянтным и снижающим уровень холестерина действиями |
|
Активное вещество |
Аминофиллин |
Пентоксифиллин |
Никотиновая кислота |
|
Показания |
Астма, апноэ, нарушения кровообращения, левожелудочковая или сердечная недостаточность, отечный синдром почечного генеза |
Нарушения периферического кровообращения, мозгового кровотока, атеросклероз, дисциркуляторная энцефалопатия, эндаартериит |
Пеллагра, атеросклероз, гастрит, спазм сосудов, неврит лицевого нерва, длительно незаживающие раны и язвы |
|
Способ применения |
1-3 раза в день по 150 мг курсом, длительность которого определяется врачом |
По 2 таблетки трижды в день курсом 1-2 месяца |
По 50 мг дважды в сутки |
|
Противопоказания |
Гипотензия, тахиаритмия, гипертензия, инсульт, эпилепсия, возраст до 12 лет |
Острый инфаркт миокарда, кровоизлияния в мозг или сетчатку, беременность, возраст до 18 лет |
Артериальная гипертензия, обострение язвенной болезни желудка, цирроз, гепатит, сахарный диабет, подагра |
|
Особые указания |
У пожилых людей доза корректируется, во время терапии нельзя пить крепкий чай и кофе |
С осторожностью применяется при артериальной гипотензии, курение понижает эффективность препарата |
Принимается только с пищей, запрещен прием с горячей едой или алкоголем |
|
Побочные эффекты |
Головокружение, снижение давления, тошнота, гематурия, кожная сыпь, боль в груди |
Головная боль, гиперемия кожи, сухость во рту, нарушение зрения, тахикардия, зуд |
Приливы крови к лицу, парестезия, гиперемия кожи, крапивница, судороги |
|
Цена, рублей |
11 за 30 таблеток |
60 за 60 таблеток |
25 за 50 таблеток |


Опыт других людей
Сосудорасширяющие препараты для головного мозга при остеохондрозе шеи вызывают смешанные отзывы у людей. Некоторые отмечают их эффективность в улучшении кровообращения и снижении головных болей, связанных с остеохондрозом. Однако другие указывают на возможные побочные эффекты, такие как головокружение и тошнота. Важно проконсультироваться с врачом перед началом приема таких препаратов, чтобы подобрать оптимальную дозировку и избежать нежелательных последствий.
Ноотропы
Сосудорасширяющие препараты для головного мозга при остеохондрозе из группы ноотропов положительно влияют на работу центральной нервной системы, улучшают память. К ним относятся:
|
Пирацетам |
Циннаризин |
Винпоцетин |
|
|
Действие |
Активирует ассоциативные, интеллектуальные процессы, улучшает связи между полушариями, устраняет последствия гипоксии |
Блокирует кальциевые каналы, выраженно влияет на работу сосудов головного мозга, улучшает кровообращение, снижает тонус гладкой мускулатуры |
Улучшает кровообращение и метаболизм головного мозга, обладает антигипоксическим и антиагрегационным свойствами, усиливает кровоток, стимулирует обмен веществ |
|
Активное вещество |
Пирацетам |
Циннаризин |
Винпоцетин |
|
Показания |
Цереброваскулярная недостаточность, ишемический инсульт, деменция, нейроинфекции, вестибулярный нистагм |
Спазм сосудов, инсульт, атеросклероз, черепно-мозговые травмы, лабиринтные расстройства, болезнь движения, диабетическая ангиопатия |
Сосудистые заболевания глаз, атеросклероз, инсульт, болезнь Меньера, деменция |
|
Способ применения |
По 800 мг в три приема курсом 0,5-6 месяцев (после еды или натощак) |
По 25 мг трижды в сутки после еды |
По 1-2 таблетки трижды в сутки курсом 2 месяца |
|
Противопоказания |
Почечная недостаточность, геморрагический инсульт, ажитированная депрессия, болезнь Гентингтона, возраст до года, лактация, беременность |
Болезнь Паркинсона, беременность, грудное вскармливание, непереносимость компонентов, пониженная свертываемость крови |
Ишемическая болезнь сердца, лактация, беременность, нарушения сердечного ритма, острый геморрагический инсульт |
|
Особые указания |
Может применяться при алкоголизме, существует способ введения препарата инъекционно |
Перорально препарат может использоваться у детей в половине взрослой дозы |
С осторожностью принимается при аритмии, стенокардии, пониженном сосудистом тонусе, неустойчивом давлении |
|
Побочные эффекты |
Сонливость, тошнота, увеличение массы тела, гипотензия, гиперчувствительность кожи |
Сухость во рту, диспепсия, аллергия, кожная сыпь, сонливость |
Снижение давления, тахикардия, экстрасистолия, замедление проводимости импульсов внутри желудочков |
|
Цена, рублей |
30 за 20 капсул |
40 за 50 таблеток |
80 за 50 таблеток |

Средства для наружного применения
Сосудорасширяющие препараты при шейном остеохондрозе для наружного применения используют при ослаблении приступов болезни. Они отличаются меньшим количеством противопоказаний, мягким действием и отсутствием дискомфорта. Мази для улучшения работы головного мозга:
|
Абифлор |
Гэвкамен |
Меновазин |
|
|
Действие |
Укрепляет, расширяет стенки сосудов, восстанавливает их проводимость, повышает эластичность, купирует боль, улучшает снабжение кислородом |
Обладает слабым противовоспалительным, выраженным местнораздражающим и отвлекающим действиями, приводит к разжижению отечного экссудата |
Раздражает нервные окончания, расширяет сосуды, обезболивает, понижает чувствительность нервных волокон |
|
Активное вещество |
Экстракт пихты (богат флавоноидами), липодерм, янтарная, аскорбиновая кислоты, рутин |
Камфора, ментол, гвоздичное и эвкалиптовое масла |
Спиртовой раствор на основе ментола, прокаина и бензокаина |
|
Показания |
Расстройства коронарного кровообращения, венозного оттока, отеки, повышенный уровень холестерина |
Остеоартроз, артралгия, невралгия, миалгия, головная кластерная боль, растяжения мышц, связок |
Невралгия, артралгия, миалгия |
|
Способ применения |
Втирать в пораженное место три раза в сутки курсом 30 дней |
Втирать небольшое количество мази 3-4 раза в день курсом 3-5 дней, после сделать перерыв на 2-3 дня |
Растирают больное место 2-3 раза в день курсом не дольше 3-4 недель |
|
Противопоказания |
Индивидуальная непереносимость компонентов состава, аллергия на эфирные масла |
Нарушение целостности кожных покровов, детский возраст, непереносимость компонентов препарата |
Воспалительные процессы, возраст до 18 лет, непереносимость компонентов, нарушение целостности кожи, лактация, вынашивание ребенка |
|
Особые указания |
Не является лекарством, может применяться с целью профилактики дважды в год |
2-4 г мази хватает для обработки площади 800 коленного сустава и крестца |
Не применять у детей до 12 лет, не наносить на лицо, на поврежденную и с проявлениями аллергичности кожу |
|
Побочные эффекты |
Жжение, раздражение кожи, чувство тепла, аллергия, кожная сыпь, крапивница |
Жжение, покалывание кожи, ощущение холода в месте аппликации |
Аллергия, крапивница, зуд, отек кожи, сыпь, гиперемия, раздражение кожного покрова |
|
Цена, рублей |
30 за 30 г |
45 за 25 г |
70 за 50 мл раствора |

Видео
Внимание!
Информация, представленная в статье, носит ознакомительный характер. Материалы статьи не призывают к самостоятельному лечению. Только квалифицированный врач может поставить диагноз и дать рекомендации по лечению, исходя из индивидуальных особенностей конкретного пациента.
Статья обновлена: 17.07.2018
Частые вопросы
Какие препараты назначают для улучшения мозгового кровообращения при шейном остеохондрозе?
Актовегин 4.Аминалон 3.Анвифен 2.Бетагистин 4.Бетагистин-верте 4.Бетагистин-озон 5.Бетасерк 5.Билобил 5.Ещё
Как улучшить кровообращение при шейном остеохондрозе?
При остеохондрозе, осложнённом дистонией, назначаются хондропротекторы, противовоспалительные и седативные препараты, миорелаксанты, антидепрессанты, бета-адреноблокаторы, ЛФК, массаж, электрофорез, физиотерапия магнитным полем – она даёт возможность стимулировать мозговое кровообращение и насытить ткани кислородом.
Что очень хорошо помогает при шейном остеохондрозе?
Диклофенак натрия. Эффективные болеутоляющие в виде гелей, мазей, таблеток, инъекций, противопоказанные детям, а также женщинам в период беременности и лактации. … Ибупрофен. … Индометацин. … Кетопрофен. … Кеторолак. … Нимесулид.
Какой самый лучший препарат для мозгового кровообращения?
№12 – «Пикамилон» (таблетки) Является лучшим лекарством для сосудов головного мозга благодаря тому, что оказывает комплексное действие – нормализует метаболизм и восстанавливает мозговое кровообращение.
Полезные советы
СОВЕТ №1
Перед началом приема сосудорасширяющих препаратов для головного мозга при остеохондрозе шеи, обязательно проконсультируйтесь с врачом. Только специалист сможет подобрать оптимальное лечение и дозировку с учетом вашего состояния.
СОВЕТ №2
Помимо приема препаратов, важно следить за своим образом жизни: избегать переутомления, правильно распределять физическую нагрузку, вести активный образ жизни и правильно питаться.